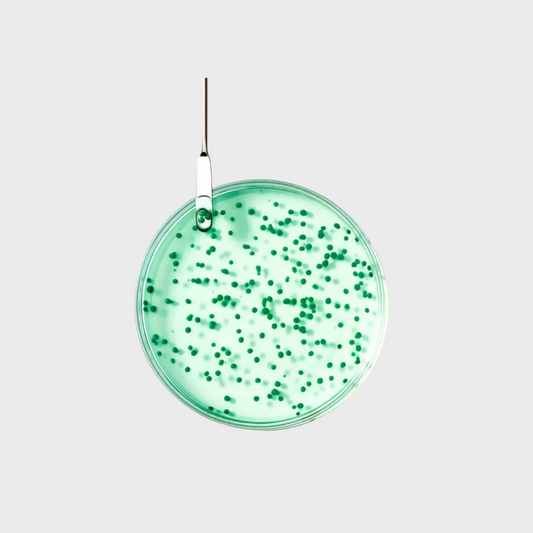
Forticea Fortifying and Revitalizing Shampoo with Vitamins

Discover Your Beauty Formula
Personalized treatments and skincare to achieve your best skin and defy aging.
-
Astera Fresh Soothing Freshness Shampoo
Regular price $42.00 CADRegular priceUnit price / perSale price $42.00 CAD -
Forticea Strengthening tonic Lotion - Menthol & Essential oils
Regular price $62.00 CADRegular priceUnit price / perSale price $62.00 CAD -
Forticea Fortifying and Revitalizing Shampoo with Vitamins
Regular price $42.00 CADRegular priceUnit price / perSale price $42.00 CAD -
Forticea Strengthening Conditioner
Regular price $42.00 CADRegular priceUnit price / perSale price $42.00 CAD -
HEAD SPA Soothing Freshness & Purity Concentrate
Regular price $62.00 CADRegular priceUnit price / perSale price $62.00 CAD -
HEAD SPA Purifying scrub - Detox
Regular price $62.00 CADRegular priceUnit price / perSale price $62.00 CAD -
5 Sens Enhancing Shampoo
Regular price $38.00 CADRegular priceUnit price / perSale price $38.00 CAD -
5 Sens Enhancing Detangling Conditioner
Regular price $39.00 CADRegular priceUnit price / perSale price $39.00 CAD -
Sublime Karité Professional Smoothing Milk
Regular price $45.00 CADRegular priceUnit price / perSale price $45.00 CAD -
NEOPUR Balancing Shampoo for Oily, Flaking Scalps
Regular price $39.00 CADRegular priceUnit price / perSale price $39.00 CAD -
NEOPUR Balancing Shampoo for Dry, Flaking Scalp
Regular price $39.00 CADRegular priceUnit price / perSale price $39.00 CAD -
Curbicia Purifying Lightness Shampoo
Regular price $80.00 CADRegular priceUnit price / perSale price $80.00 CAD